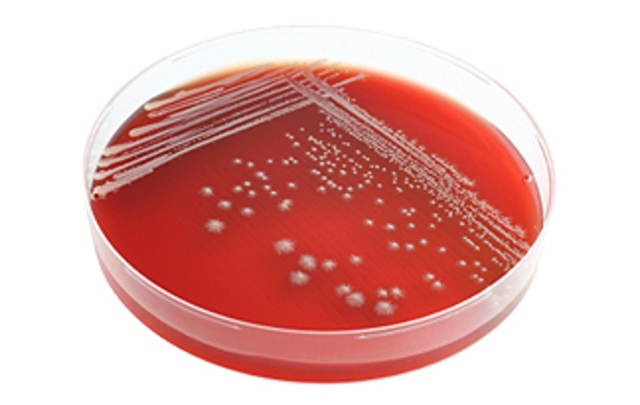
Penicillin was invented

-
-
The United States added the 18th ammendment to the Constitutuion. This put a ban on alcohol in the Untied States.
-
F. Scott Fitzgerald first novel "This Side of Paradise" was published. Fitzgerald became a hit overnight
-
F. Scott Fitzgerald married Zelda Sayre in New York.
-
The 19th ammendment to the Constitution was ratified on August 20, 1920. This gave women the right to vote
-
In the 1920 World Series, the Cleaveland Indians defeated the Brooklyn Dodgers 5 games to 2. It was the first time there was a grand slam in a World Series and the second time there was an unassisted triple play.
-
The newly wed couple made their first trip to Europe.
-
Frances Scott Fitzgerald, their daughter, an only child, was born.
-
Fitzgerald published his second novel, "The beautiful and the Damned"
-
The Charleston dance became widley popular during the year 1923. The dance became popular after appearing along with the song, "The Charleston," by James P. Johnson in the Broadway musical "Runnin' Wild"
-
In 1923 the first issue of Time Magazine was published
-
To escape to a more peaceful place, the Fitzgerald family moved to France in 1924
-
The first winter olympic games were held in Charmonix, France. 16 countries participated.
-
The Fitzgerald family spent the winter of 1924-1925 in Rome. They were on their way home when The Great Gatsby was published
-
F. Scott Fitzgerald published what would become one of the best American novels, The Great Gatsby.
-
The first edition of Winnie the Pooh was published on October 14, 1926 by A.A. Milne
-
-
On September 30, 1927, Babe Ruth hit his 60th homerun in a single season. This set a record that would stand for 34 years
-
To get away form the distractions of France, the F. Scott Fitzgerald, Zelda and Frances moved back to the United States. After failing at screen writing for Broadway, they settled in Delaware for 2 years
-
Bubble gum was invented in 1928 on accident by Walter Diemer
-
Penicillin was invented in 1928 by Alexander Flemming. He left some petri dishes out before he went on vacation and came back to mold. He saw the potential and today Penicillin is still a widley used drug.
-
Mickey Mouse made his first ever television appearance.
-
On March 4, 1929, Herbert Hoover was inaugurated as the 31 president of the United States. He served from 1929 to 1933.
-
On October 29, 1929 the stock market crashed on Wall Street. This marked the beginning of the Great Depression
-
Zelda checked herself into a sanitorium in 1930, just outside of Paris. Fitzgerald lived in hotels while she was there for 12 weeks. Zelda was diagnosed as schizophrenic, although she was most likely misdiagnosed. After this episode, Zelda would spend time in and out of mental clinics until her death in 1948. Her relationship with Fitzgerald slowly died.
-
Clyde W. Tombough discovered the little ice planet on February 18, 1930.
Plan projects on a visual timeline
Map milestones, phases, deadlines, and key events in one place so the sequence is easier to see and share. Timetoast is a timeline maker for work, school, research, and stories.